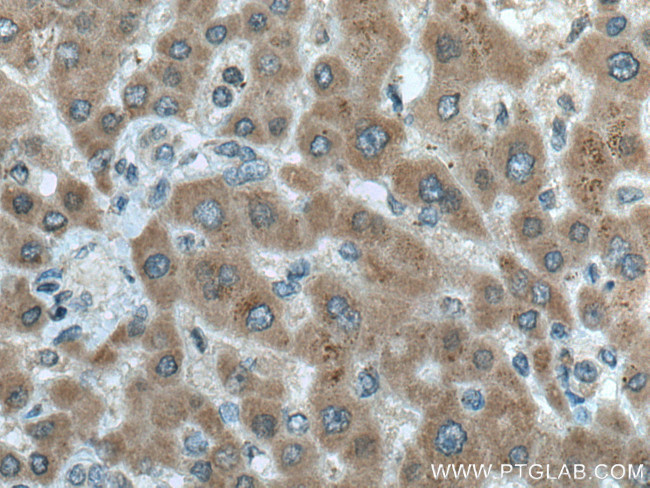
ERN2 Antibody in Immunohistochemistry (Paraffin) (IHC (P))

Search
Proteintech
ERN2 Monoclonal Antibody (2G6A10)
{{$productOrderCtrl.translations['antibody.pdp.commerceCard.promotion.promotions']}}
{{$productOrderCtrl.translations['antibody.pdp.commerceCard.promotion.viewpromo']}}
{{$productOrderCtrl.translations['antibody.pdp.commerceCard.promotion.promocode']}}: {{promo.promoCode}} {{promo.promoTitle}} {{promo.promoDescription}}. {{$productOrderCtrl.translations['antibody.pdp.commerceCard.promotion.learnmore']}}
产品信息
67289-1-IG
种属反应
宿主/亚型
分类
类型
克隆号
抗原
偶联物
形式
浓度
纯化类型
保存液
内含物
保存条件
运输条件
产品详细信息
Aliquoting is unnecessary for -20°C storage.
靶标信息
ERN2 serine/threonine kinase or endoplasmic reticulum to nucleus signaling 2 protein is a human homologue of the yeast Ire1 gene product which plays a role in multiple facets of the ER stress response in mammalian cells. This pro-apoptotic appears to play no role in the unfolded-protein response, unlike closely related proteins. Overexpression of ERN2 activates both BiP and CHOP expression, and also leads to the development of programmed cell death. It has been suggested that Ern2 plays a role in multiple facets of the ER stress response in mammalian cells.
仅用于科研。不用于诊断过程。未经明确授权不得转售。
篇参考文献 (0)
生物信息学
蛋白别名: endoplasmic reticulum to nucleus signalling 2; Endoplasmic reticulum-to-nucleus signaling 2; ER to nucleus signalling 2; hIRE2p; inositol-requiring 1 beta; Inositol-requiring protein 2; IRE1 beta; IRE1, S. cerevisiae, homolog of; Ire1-beta; IRE1b; Serine/threonine-protein kinase/endoribonuclease IRE2
基因别名: ERN2; hIRE2p; IRE1-BETA; IRE1b; IRE2; IRE2p
UniProt ID: (Human) Q76MJ5
Entrez Gene ID: (Human) 10595